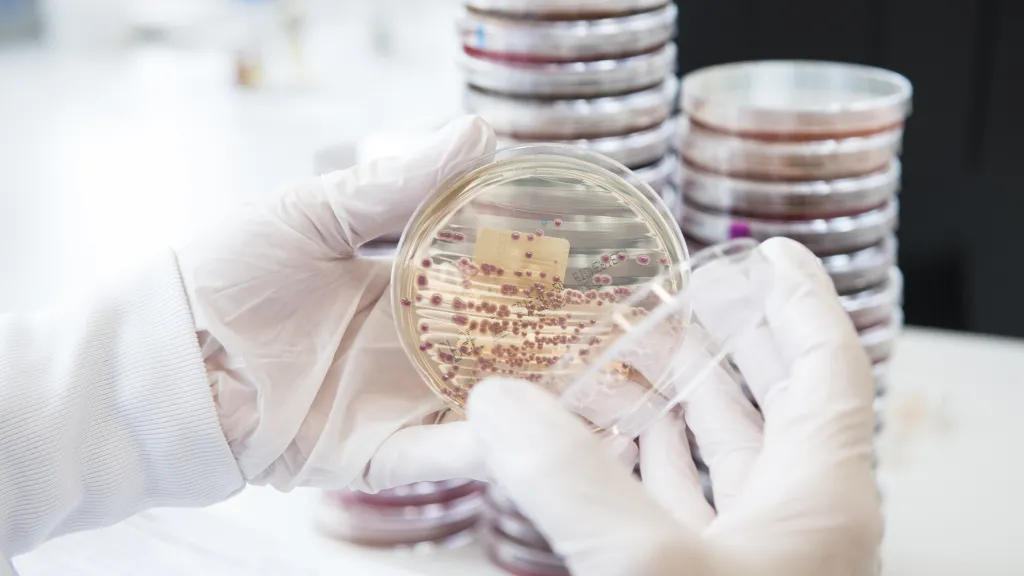
Entérobacteria - HUG

You have activated the high contrast version of the site. For more info on this topic, please visit this page.
Press releases
Le service des médias des HUG informe régulièrement les journalistes par le biais de communiqués, de dossiers et de conférences de presse.
Si vous êtes journaliste et souhaitez recevoir nos informations, inscrivez-vous à notre liste de diffusion.
Wednesday 11 December 2024
Call for abstracts now open for the 48th World Hospital Congress – Geneva 2025
Wednesday 27 November 2024
The role of social media in the stigmatization of person living with obesity
Tuesday 05 November 2024
New criteria to avoid the over-diagnosis of Alzheimer’s Disease
Thursday 26 September 2024
Programming cells to target brain tumours
Thursday 23 May 2024
10th Geneva Health Forum will discuss health, environment and migration
Wednesday 24 April 2024
Robert Mardini is the new Director general of the University Hospital of Geneva
Thursday 15 February 2024
European consensus for the diagnosis of Alzheimer’s disease
Monday 08 January 2024